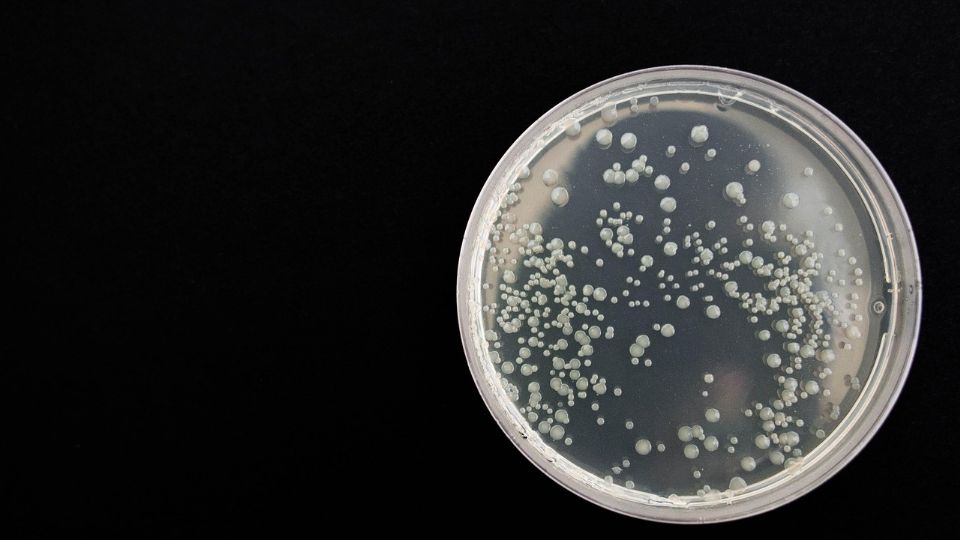

El Gobierno federal revocó la licencia sanitaria de una filial de PiSA Farmacéutica tras su vinculación con varios brotes bacterianos, incluyendo el de Klebsiella oxytoca, que resultó en la muerte de 13 niños en el Estado de México a finales de 2024.
A finales de 2024, México registró su primer brote de Klebsiella oxytoca, una bacteria altamente resistente que provoca infecciones graves en vías urinarias, neumonías, sepsis, piel y tejidos blandos. Ante esta situación, la Secretaría de Salud emitió una alerta epidemiológica para todas las unidades médicas del país.
El brote, con 20 casos y 15 confirmados, afectó principalmente a hospitales públicos y privados en el Estado de México. La mayoría de los pacientes son neonatos y niños de entre 0 y 14 años.
Te podría interesar
Klebsiella oxytoca es una bacteria gram-negativa, aerobia y no esporulada del género Klebsiella. Se encuentra en el tracto gastrointestinal de humanos y animales, así como en diversos entornos ambientales.
La bacteria representa un riesgo especialmente alto para personas con sistemas inmunitarios comprometidos. Las infecciones más comunes relacionadas con Klebsiella oxytoca incluyen:
Infecciones del tracto urinario, especialmente en pacientes con catéteres.
Neumonía, más frecuente en personas con enfermedades pulmonares crónicas y neonatos prematuros.
Infecciones de la piel y tejidos blandos, particularmente en personas con heridas abiertas.
Sepsis, una condición potencialmente mortal en casos graves.
Las autoridades de salud mantienen vigilancia epidemiológica y han emitido recomendaciones para prevenir nuevos brotes.
Contexto: En su momento, la empresa que suministraba el alimento para bebés que estaría relacionada con la infección con la bacteria Klebsibella oxytoca y la muerte de 13 infantes en distintos hospitales del Estado de México fue suspendida, así como el contrato que tenía, anunció la presidenta Claudia Sheinbaum.
La Secretaría de Salud informó que el brote estaría relacionado con una posible contaminación de Nutrición Parenteral (NPT) para bebés o de los insumos utilizados para su aplicación, por lo que la Comisión Federal para la Protección contra Riesgos Sanitarios (Cofepris) emitió una alerta sobre la posible contaminación de los lotes de NPT producidos por la empresa Productos Hospitalarios S.A. de C.V., ubicada en el Estado de México.
Como medida preventiva, se ordenó la inmovilización de estos productos; sin embargo, a pesar de realizar una inspección en la central de mezclas donde se elaboraron, no se encontraron hallazgos críticos en las instalaciones.
ÚNETE A NUESTRO CANAL DE WHATSAPP. EL PODER DE LA INFORMACIÓN EN LA PALMA DE TU MANO
SÍGUENOS EN EL SHOWCASE DE GOOGLE NEWS
djh